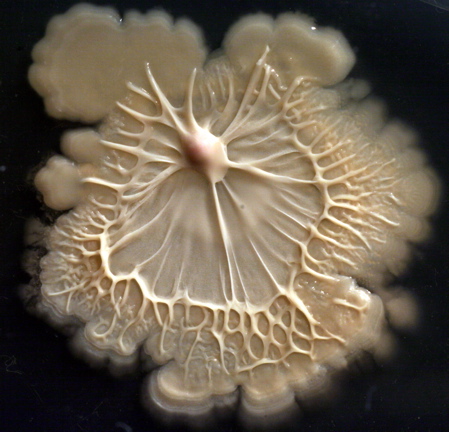
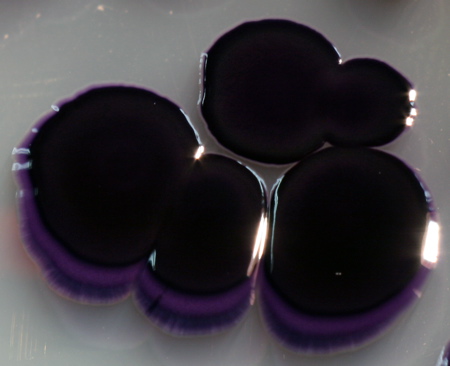

Different bacterias ...
different look. Not all look the same.


colonies of a bacillus strain


colonies of a streptomyces
strain
colonies of a streptomyces strain


colonies of a streptomyces
strain
lactobacillus culture


colonies of
janthinobacterium
lividum
streptomyces
colonies


rhodococcus ruber
streptomcyes colonies